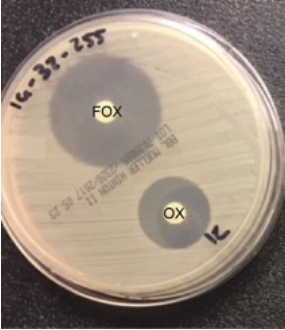

1/
TIL about BORSA/MODSA, so cue the #IDTwitter #Tweetorial.
Thanks to the many contributors on @DrDidwania_ID's post on a very interesting variation of Staph aureus that phenotypically matches MRSA, but does not carry the correct genotype.
/thread
TIL about BORSA/MODSA, so cue the #IDTwitter #Tweetorial.
Thanks to the many contributors on @DrDidwania_ID's post on a very interesting variation of Staph aureus that phenotypically matches MRSA, but does not carry the correct genotype.
/thread
https://twitter.com/DrDidwania_ID/status/1532900924276060160?s=20&t=TeetlhAUSb230Iwbp3zDsg
2/
Methicillin resistance is usually conferred by an altered penicillin-binding protein (PBP2a) via the gene mecA (or sometimes mecC).
MecA is detected by current molecular testing as a marker of methicillin-resistance for Staphylococcal species
link.springer.com/chapter/10.100…
Methicillin resistance is usually conferred by an altered penicillin-binding protein (PBP2a) via the gene mecA (or sometimes mecC).
MecA is detected by current molecular testing as a marker of methicillin-resistance for Staphylococcal species
link.springer.com/chapter/10.100…

3/
What is BORSA & MODSA?
BORSA: borderline oxacillin-resistant Staph aureus
MODSA: modified Staph aureus
Just add this to MSSA, MRSA, VISA, and VRSA in the genre of Staph aureus-related acronyms!!
Key article I referenced for this thread: pubmed.ncbi.nlm.nih.gov/28893360/
What is BORSA & MODSA?
BORSA: borderline oxacillin-resistant Staph aureus
MODSA: modified Staph aureus
Just add this to MSSA, MRSA, VISA, and VRSA in the genre of Staph aureus-related acronyms!!
Key article I referenced for this thread: pubmed.ncbi.nlm.nih.gov/28893360/
4/
BORSA is defined by borderline resistance to antistaphylococcal penicillins with an oxacillin MIC of 1-8.
But, there is no PBP2a or mecA/C present...🧐
So other mechanisms of resistance must be present.
mdpi.com/2079-6382/9/4/…
BORSA is defined by borderline resistance to antistaphylococcal penicillins with an oxacillin MIC of 1-8.
But, there is no PBP2a or mecA/C present...🧐
So other mechanisms of resistance must be present.
mdpi.com/2079-6382/9/4/…

5/
The main mechanism of resistance for BORSA is hyperproduction of beta-lactamases.
Meaning this resistance could be overcome with a beta-lactamase inhibitor, e.g., clavulanate, as suggested by @wfwrighID
But, other mechanisms may be at play too.
The main mechanism of resistance for BORSA is hyperproduction of beta-lactamases.
Meaning this resistance could be overcome with a beta-lactamase inhibitor, e.g., clavulanate, as suggested by @wfwrighID
But, other mechanisms may be at play too.
https://twitter.com/wfwrighID/status/1533075360648241155?s=20&t=rg0US9HOG5yxfYFKGfyb5g
6/
Other mechanisms for BORSA resistance:
- Modification of PBP genes (e.g., PBP3 & 4) - these strains are called MODSA
- Plasmid-encoded beta-lactamases (e.g., BlaZ serving as an ESBL)
sciencedirect.com/science/articl…
Other mechanisms for BORSA resistance:
- Modification of PBP genes (e.g., PBP3 & 4) - these strains are called MODSA
- Plasmid-encoded beta-lactamases (e.g., BlaZ serving as an ESBL)
sciencedirect.com/science/articl…
7/
So how do you know if your strain is BORSA?
Well, you might not know, as it is frequently misidentified as MRSA or MSSA
Using cefoxitin disc methods, BORSA will appear to be MSSA, as cefoxitin induces mecA only
So how do you know if your strain is BORSA?
Well, you might not know, as it is frequently misidentified as MRSA or MSSA
Using cefoxitin disc methods, BORSA will appear to be MSSA, as cefoxitin induces mecA only
8/
If using traditional susceptibility testing, the MIC of BORSA appears consistent with MRSA.
BORSA defined as oxacillin MIC 1-8
CLSI cut-off for MRSA is oxacillin MIC ≥4
If using traditional susceptibility testing, the MIC of BORSA appears consistent with MRSA.
BORSA defined as oxacillin MIC 1-8
CLSI cut-off for MRSA is oxacillin MIC ≥4
9/
The clue for BORSA is phenotypic resistance consistent with MRSA with absence of PBP2a/mecA or a negative cefoxitin disc
This is the case that @DrDidwania_ID presented!
The clue for BORSA is phenotypic resistance consistent with MRSA with absence of PBP2a/mecA or a negative cefoxitin disc
This is the case that @DrDidwania_ID presented!
https://twitter.com/DrDidwania_ID/status/1532900924276060160?s=20&t=TeetlhAUSb230Iwbp3zDsg
10/
So how do you treat BORSA, as it is neither MRSA nor MSSA?
Practically, you treat BORSA just like MRSA.
However, if you can demonstrate a 2-fold decrease in MIC with use of a beta-lactamase inhibitor, then a BL/BLI could be used
So how do you treat BORSA, as it is neither MRSA nor MSSA?
Practically, you treat BORSA just like MRSA.
However, if you can demonstrate a 2-fold decrease in MIC with use of a beta-lactamase inhibitor, then a BL/BLI could be used
11/
In summary:
💥 BORSA: borderline oxacillin-resistant Staph aureus
💥 Resistance mediated by beta-lactamases
💥 No mecA or PBP2a, negative cefoxitin disc
💥 Treat similar to MRSA
In summary:
💥 BORSA: borderline oxacillin-resistant Staph aureus
💥 Resistance mediated by beta-lactamases
💥 No mecA or PBP2a, negative cefoxitin disc
💥 Treat similar to MRSA
12/
Thanks again to the commenters on @DrDidwania_ID's fascinating post for teaching.
Tagging amplifiers & those interested. Welcoming comments, as I just learned about this today!
@dralicehan @alxpenguin @IdVilchez @ID_fellows @wfwrighID @DrToddLee @Cortes_Penfield @UNMC_ID
Thanks again to the commenters on @DrDidwania_ID's fascinating post for teaching.
Tagging amplifiers & those interested. Welcoming comments, as I just learned about this today!
@dralicehan @alxpenguin @IdVilchez @ID_fellows @wfwrighID @DrToddLee @Cortes_Penfield @UNMC_ID
• • •
Missing some Tweet in this thread? You can try to
force a refresh

















